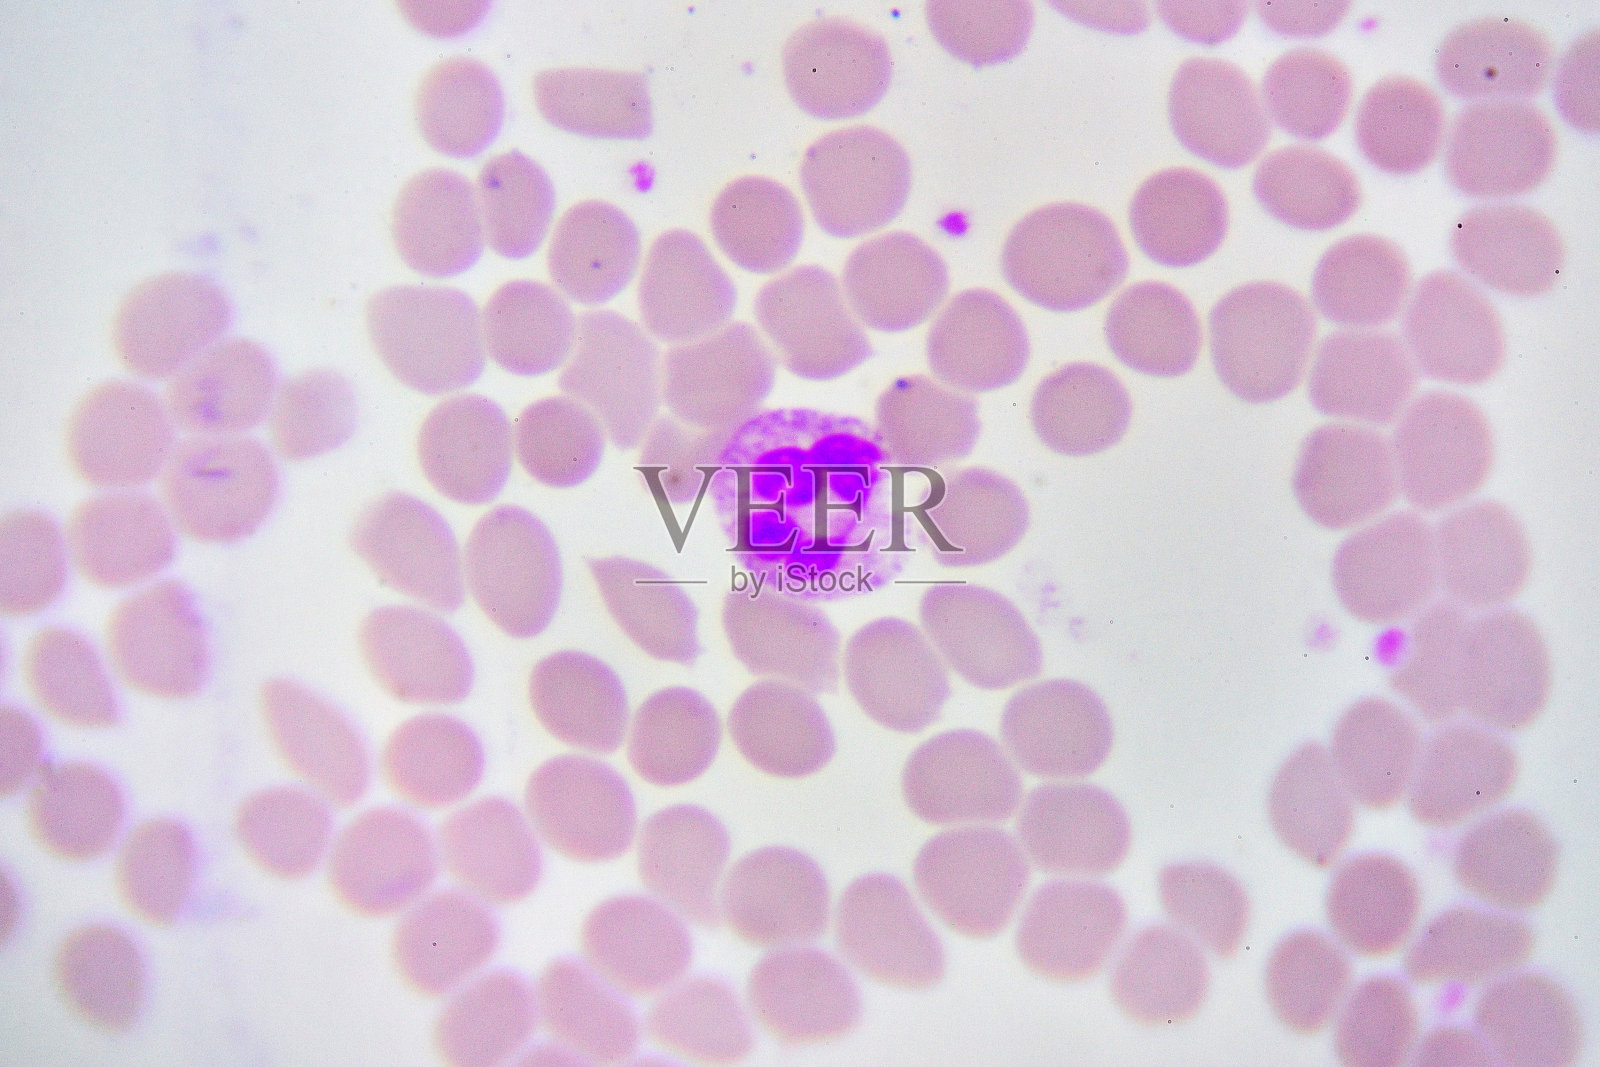
白细胞照片摄影图片

白细胞照片摄影图片
白细胞照片摄影图片作品是由来自微利图库鼻祖iStock的中国站-Veer图库提供,作品作者是:jarun011;图片ID:304724610;最大尺寸:5006x3337px;存储大小:14.87MB;当前优质版权图片内容提供下载与正版授权服务,助力您的品牌提升 。
版权声明
本网站图片、视频、音乐、设计、字体等版权作品,均由本网站或版权所有人授权本网站发布,本网站有权提供版权授权使用许可。如您需将版权作品用于包括但不限于公开媒介发布、设计、展示、推广及其他等用途,请联系本网站签订协议,支付版权许可使用费。需授权许可范围包括但不限于社交网络媒体(微博、微信公众号)、网站、APP、书籍、报纸、期刊、电视节目、电影作品、展览、装修装饰、包装设计、广告、公关活动、宣传图册、PPT演示等。如您未经授权许可使用本网站的版权作品,则存在侵犯版权的法律风险,将依法承担法律责任。
